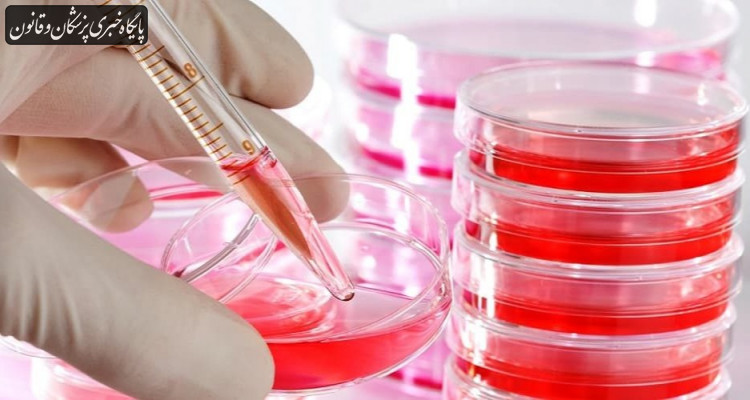

۲۷ پیوند از نمونههای بانک خون بندناف انجام شده است
مدیرعامل سازمان انتقال خون در مورد دستاوردهای فنی و فناوریهای نوین سازمان انتقال خون گفت: از چهار هزار و ۲۰۰ نمونه بانک خون بند ناف این سازمان، تاکنون ۲۷ مورد پیوند انجام شده و با بیماران تطابق یافته است.
به گزارش پایگاه خبری پزشکان و قانون (پالنا)، مصطفی جمالی با اشاره به دستاوردهای انتقال خون کشور از جمله مدیریت تأمین خون در ههگیری کرونا گفت: در زمان وقوع این بحران، کشورهای اتحادیه اروپا و آمریکا با کاهش ۲۰ تا ۲۵ درصدی ذخایر خون مواجه شدند، در صورتی که کشور ما خوشبختانه توانست با شبکه ملی خون رسانی کمترین افت را تجربه کند.
مدیرعامل سازمان انتقال خون شاخص سلامت خون در ایران را طبق گزارش WHO "سازمان جهانی بهداشت" همتراز کشورهای پیشرفته دانست و تاکید کرد: در بخش دستاوردهای فنی و فناوریهای نوین سازمان انتقال خون از چهار هزار و ۲۰۰ نمونه بانک خون بندناف این سازمان، تاکنون ۲۷ مورد پیوند انجام شده و با بیماران تطابق یافته است، در ۷۰ هزار نمونه ثبت شده در مرکز سپاس، "مرکز پذیره نویسی سلول های بنیادی غیر خویشاوند" تاکنون ۳۳ پیوند صورت گرفته است.
وی از ذخیره ۳۵۰ واحد گلبول فشرده فریزشده خونهای نادر در ایران خبر داد و افزود: ارسال موفق نمونهای از این خونها برای بانوی بارداری که در عمان نیازمند خون بود، نشانه موفقیت در همکاریهای بین المللی سلامت محور است که ایران عضوی از آنها به شمار میرود، برای سزارین این بیمار که گروه خون بسیار نادر داشت، یک اهدا کننده از شمال کشور با هماهنگی سازمان انتقال خون، نیاز بیمار را تامین کرد و از طریق پرواز و با رعایت کامل پروتکلهای زنجیره سرما این خون به وزرات بهداشت عمان منتقل شد.
جمالی ادامه داد: اگر سازمانهای بینالمللی در تامین تجهیزات و مواد مورد نیاز از سازمان انتقال خون حمایت کنند، ظرفیت داریم که ذخایر خون بندناف و آزمایشهای سازگاری بافتی انسانی "HLA typing" را به حدی توسعه دهیم که به سلامت کشورهای منطقه نیز کمک کند، روزانه ۷۰۰ کودک در کشور به خاطر نداشتن امکان آزمایشهای سازگاری بافتی و نیافتن نمونه مطابق، در معرض خطر مرگ قرار میگیرند زیرا در شرایط تحریم امکانات لازم برای استفاده از روش NGS در این روش تنها نواحی کدکننده ژنوم انسان مورد توالی یابی قرار میگیرد و توسعه پیوند سلول های بنیادی وجود ندارد، از سازمانهای بینالمللی سلامت محور درخواست داریم تا در این زمینه با در نظر گرفتن ارزشهای انسانی و حقوق بشری که اثری از آن در تحریم های اعمال شده علیه ایران دیده نمیشود، برای نجات جان انسانها در ایران اقدامی موثر انجام دهند.
به گزارش ایرنا مدیرعامل سازمان انتقال خون در پایان با اشاره به گوناگونی نژادی در ایران و مشابهت ژنتیک اقوام با کشورهای همسایه گفت: در صورت رفع موانع تحریم از اقلام دارویی و تجهیزات درمانی و توسعه بانک سلولهای بنیادی و آزمایش های تطابق بافتی، ایران میتواند برای سلامت و یاری رسانی به کشورهای منطقه نیز اثر بخش باشد، دانش و تکنولوژی موجود در ایران در حدی است که ما آمادگی داریم تا استاندارد سازی و توسعه انتقال خون کشورهای منطقه را برعهده بگیریم و اجلاس G۵به همین منظور با مشارکت کشورهای پاکستان، افغانستان و عراق برگزار خواهد شد.
پایان پیام/
نظر خود را بنویسید